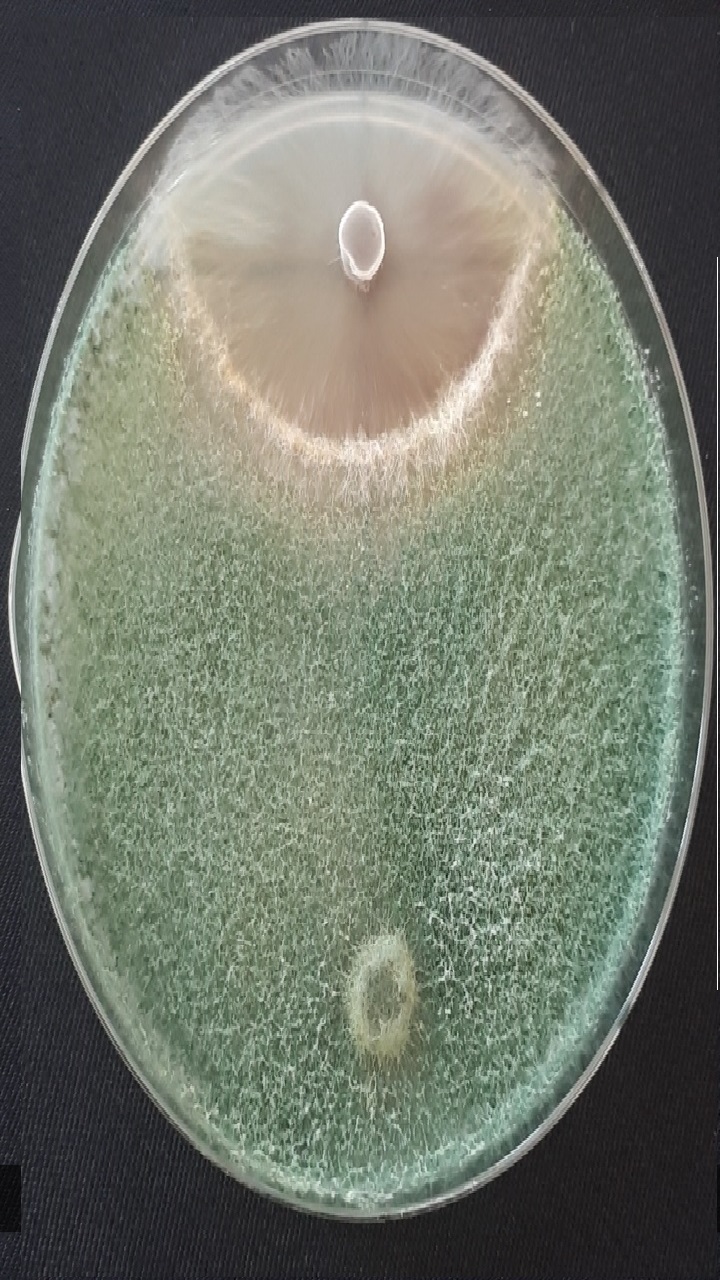

La biotechnologie de la reproduction regroupe les techniques utilisées pour contrôler et améliorer la reproduction chez les animaux et l’homme, comme l’insémination artificielle, la fécondation in vitro et le transfert embryonnaire. Elle vise à améliorer les performances génétiques, augmenter la productivité et traiter l’infertilité. Ces techniques sont largement utilisées en production animale et conservation des espèces.
The burgeoning global population, currently estimated at 7.8 billion and projected to reach nearly 10 billion by 2050, has placed immense pressure on the agricultural sector. To meet the rising demand for food, production must increase by 70% to 110%. Historically, this demand was met through conventional farming practices characterized by the intensive use of synthetic fertilizers and chemical pesticides. While these methods initially boosted yields, they have led to significant environmental degradation, including soil acidification, loss of biodiversity, and the accumulation of toxic residues in the food chain. Consequently, there is an urgent global shift towards sustainable and organic agriculture, which seeks to maintain productivity while conserving the environment and protecting human health.
At the heart of this transition are Agriculturally Important Microorganisms (AIM). These indigenous soil-dwelling communities are recognized as major stakeholders in sustainable agriculture. They interact with their micro-environment either synergistically or antagonistically, forming complex plant-microbe associations that are ecologically sustainable. The judicious involvement of these microbes offers a viable route to enhance soil fertility, improve plant health, and mitigate the adverse effects of climate change without the ecological toll of agrochemicals
- Enseignant: dahou moutassem
- Enseignant: amira sakhraoui

- Enseignant: khelifa maamri
|
Chapter 1: Basic Concepts 1. Definition of a seed 2. Seed physiology - Morphological maturation - Physiological maturation o Seed coat–imposed inhibition o Embryo dormancy 3. Concepts related to germination 4. Definition of seed production |
4h30 |
|
Chapter 2: Principles of Seed Production Introduction 1. Objectives of seed production 2. Essential practices in seed production - Selection of location/site - Isolation - Roguing - Crop management - Multiplication Factor (MF) - Seed lots and traceability - What is the starting point of seed multiplication? - Crop maturity and harvesting - Constraints related to seed production in certain crops - Contract seed growers - Production planning |
9h |
|
Chapter 3: Seed Production of Selected Agricultural Species - Main aspects related to seed production of selected cereal crops - Main aspects related to seed production of selected vegetable crops - Production of F1 hybrid varieties |
9h |
- Enseignant: zineelabidine fellahi